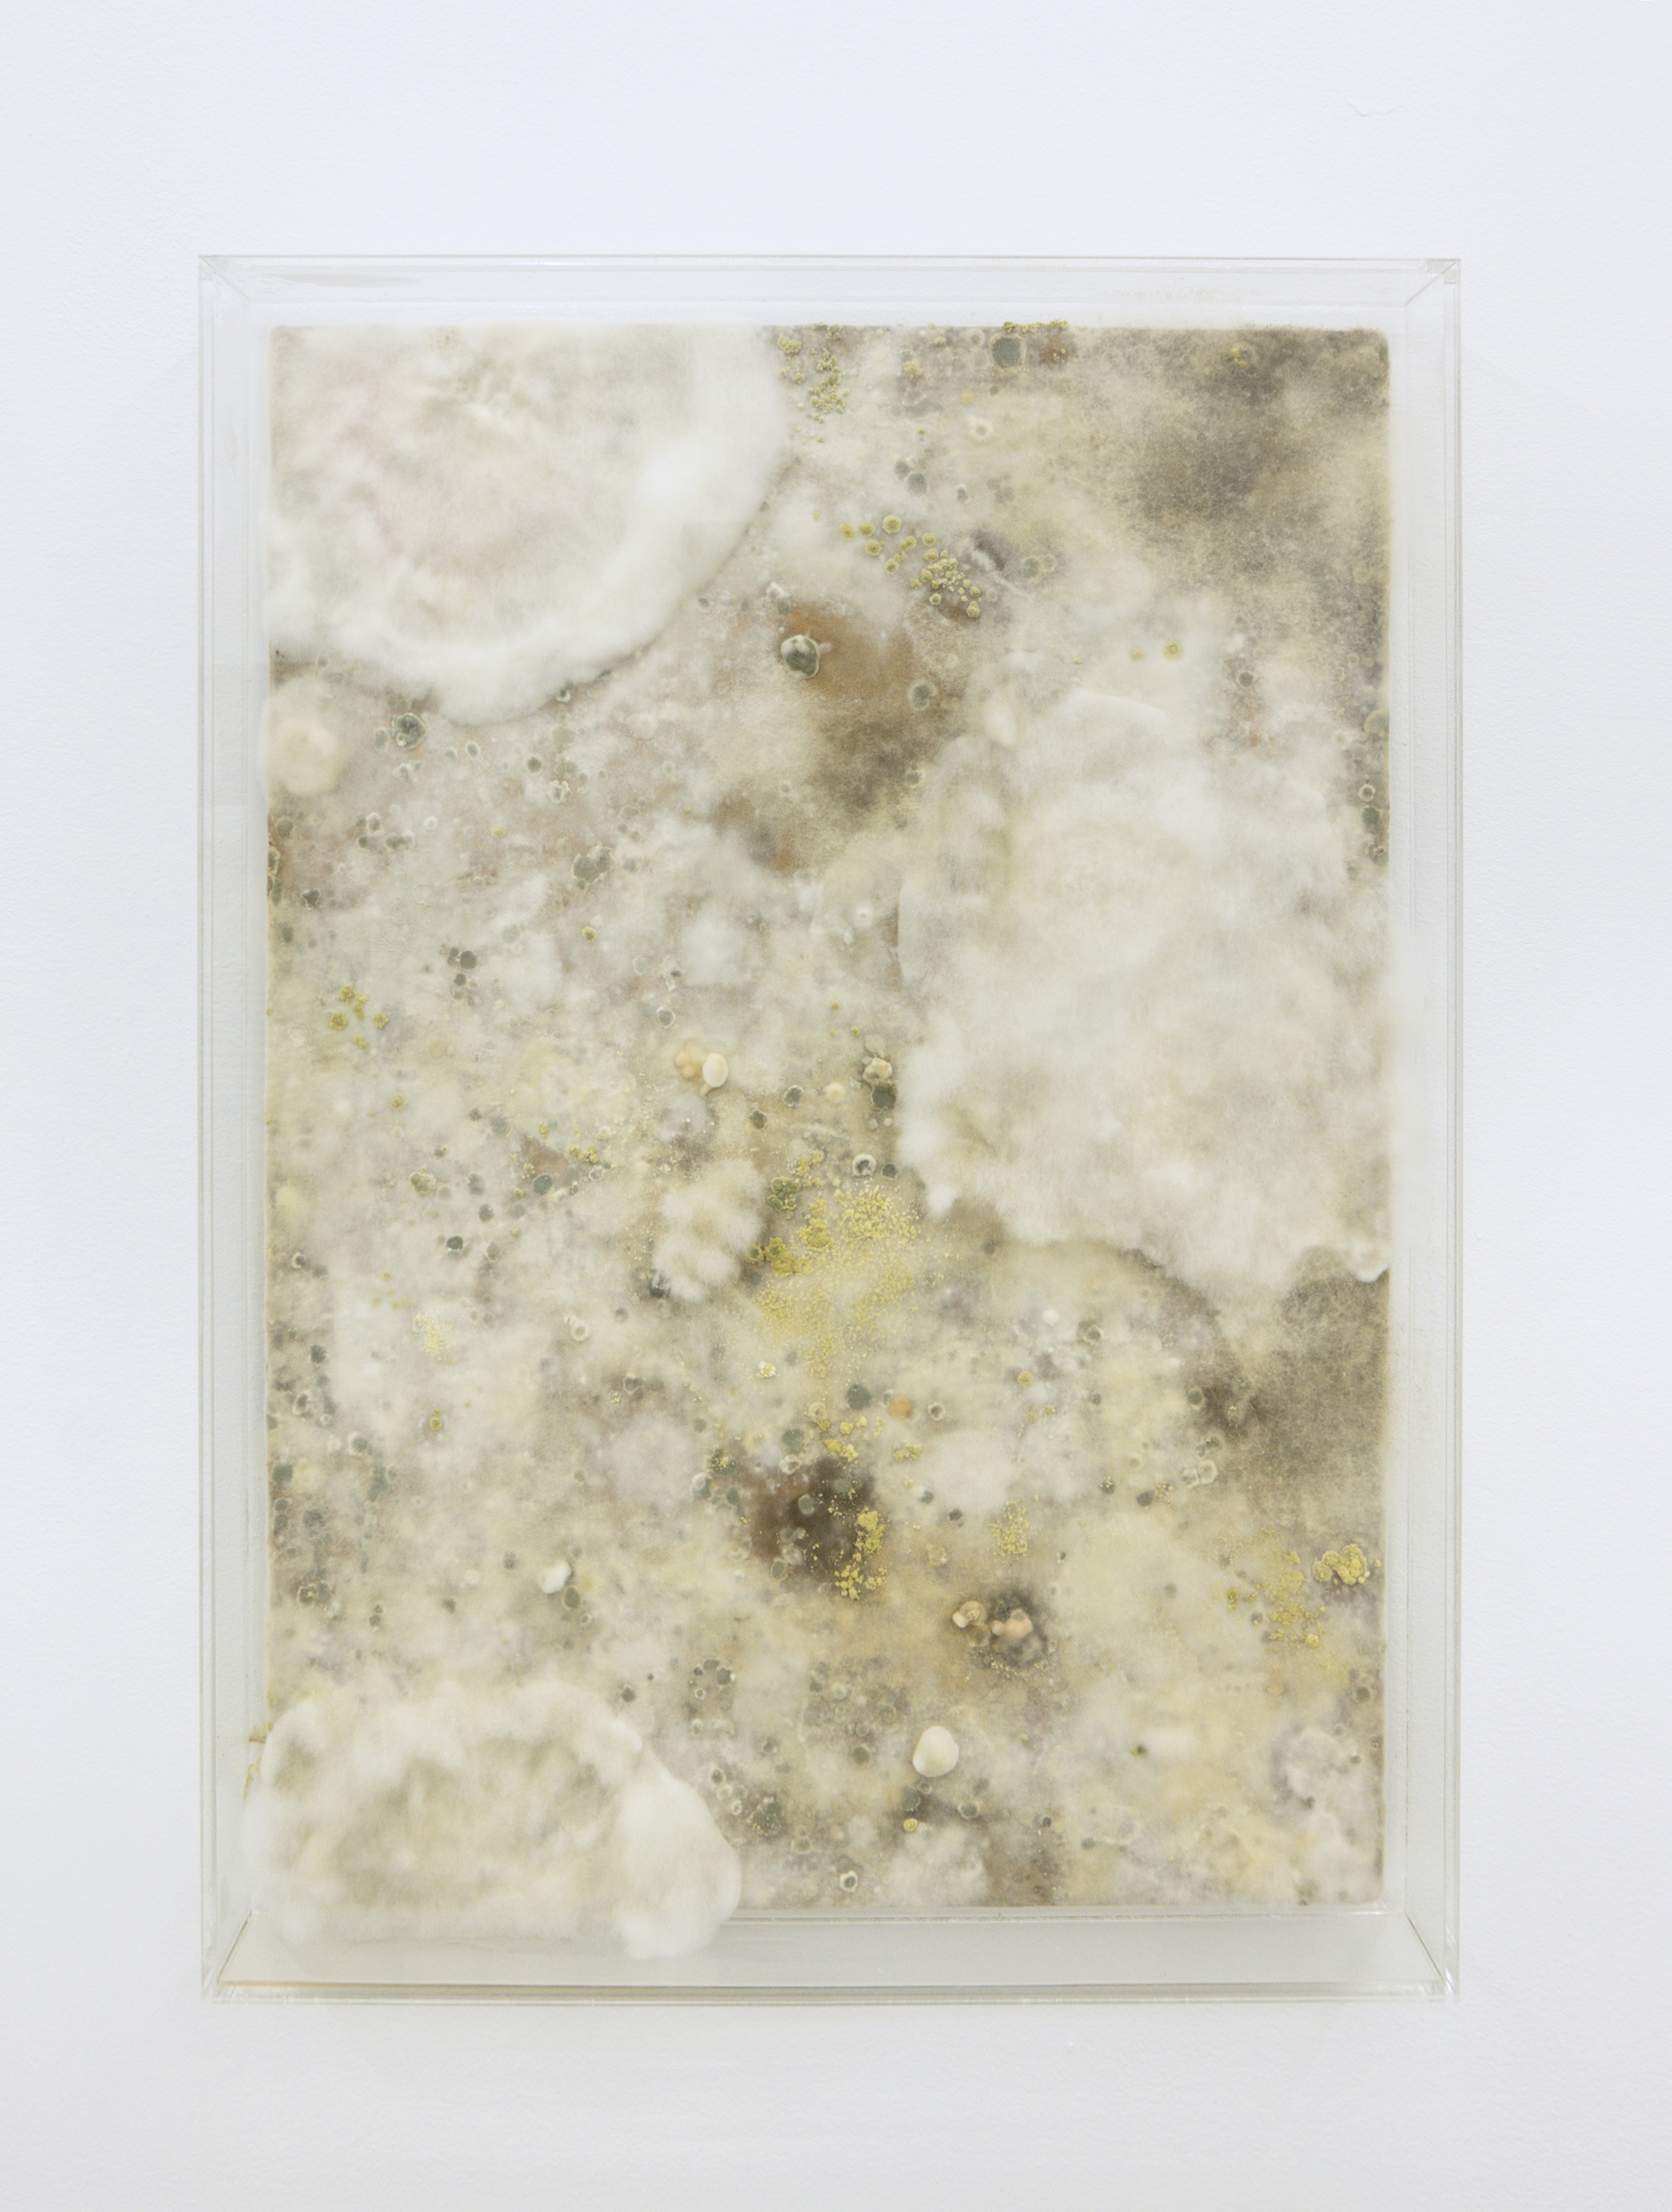

Skimmelsvamp og bolsjemasse breder sig i Formeriet under Silas Inoues ophold. Med temaet “at sætte spor” forvandler han de utraditionelle materialer til kunst, der skal indgå i en udstilling med titlen “What is left behind” på Akershus Kunstsenter i Norge.
Evigt liv i sukker og friture
Silas’ kommende udstilling omhandler det at sætte spor. Både med fokus på de aftryk mennesket sætter på kloden i den antropocæne tidsalder, og de spor en kunstner efterlader af sig selv eller af arbejdsprocessen i værksproduktionen. Hans værker til udstillingen berører samtidig emner som vækst, forfald, og præservering.
Silas har primært arbejdet på to forskellige værkserier. En form for malerier bestående af levende skimmelsvamp og en serie skulpturerer, med navnet Future Friture, bestående af store mængder sukker nedsunken i beton kar og specialfabrikerede akvarier fyldt med fritureolie.
Jeg er særligt optaget af sukker som skulpturelt materiale på grund af dets kulturelle og metaforiske betydninger, der ofte peger i retning af noget syndigt eller flygtigt, såsom begær, overfladiskhed, kunstighed og usundhed, siger Silas om sit materialevalg.
Som forlæg for sukkerskulpturene har Silas kigget på Hydraorganismen og den lille vandmand Turritopsis dohrnii, der i naturen har en meget speciel livscyklus, hvor de regenererer sig selv, når de når en vis alder. De er dermed de eneste organismer, som besidder en form for evigt liv.
Sukkerværkerne er skabt ved først at forme en træskulptur, der fungerer som en indre konstruktion for sukkermassen.Træskulpturen er sat sammen af flere mindre træstykker, bearbejdet med bl.a. hammer, motorsav, stemmejern og vinkelsliber. Herefter er træskulpturen brændt med en blæselampefor at skabe tilfældige mønstre af sod. Fordi sukkeret falder af i løbet af udstillingen, ønsker Silas at eksperimentre med det æstetiske udtryk, når træet blottes. Brændingen er et led i denne eksperimenteren.
Træskulpturen overhældes efterfølgende af et tykt lag opvarmet bolsjemasse, som en slags glasur. Silas har kogt otte kg. bolsjemasse ad gangen og givet hver skulptur flere lag inden han har været tilfreds med udtrykket. Når først bolsjemassen er størknet, har han placeret skulpturene på pidestaler støbt i cement og overhældt dem med fritureolie.
Indrammet skimmelsvamp
Den anden halvdel af Silas’ værksproduktion består af nogle vægbaserede biotoper i klar akryl, hvori skimmelsvampe udgør en form for landskab eller abstrakt maleri. Akrylkasserne har en bagbeklædning af træ, der synes at svæve i luften. Kasserne har Silas fået fremstillet industrielt og efterfølgende “malet” træbeklædningen med surmælksprodukter inden han har forseglet kassen ved at lime den sammen. Limen fungerer som en slags svejsning, idet den opløser akrylen og kassen bliver hermetisk lukket. Bag på kassen, gemt af træpladen, er et filter fra en skimmelsvampsbeskyttelsesmaske. Denne muliggør at surmælken kan bliver kultiveret af luftens naturlige bakterieflora, uden at de sundhedsskadelige sporer kan slippe ud.
Skimmelsvampe er en af naturens mest betydningsfulde nedbrydningsorganismer. Disse hårdføre vækster, der normalt forbindes med forfald, og som udgør en potentiel fare for mennesker og dyr, kan samtidig indeholde en særegen form for skønhed. Silas benytter dette udtryksmæssige potentiale, ved at kultivere skimmelsvampe i lukkede biotoper, som gør det muligt at betragte skimmelsvampenes komplekse strukturer i sikkerhed for deres sundhedsskadelige sporer, samtidig med at værkerne peger på naturens cykliske gang, og på de økologiske kollaps som konstant finder sted.